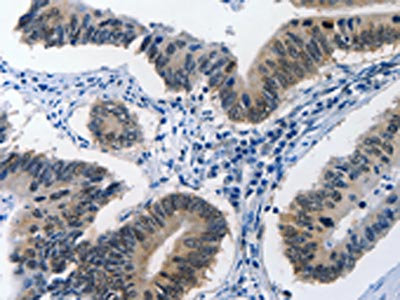

BPIFB1 Antibody
-
中文名稱:BPIFB1兔多克隆抗體
-
貨號:CSB-PA072508
-
規(guī)格:¥1100
-
圖片:
-
The image on the left is immunohistochemistry of paraffin-embedded Human colon cancer tissue using CSB-PA072508(BPIFB1 Antibody) at dilution 1/40, on the right is treated with synthetic peptide. (Original magnification: ×200)
-
The image on the left is immunohistochemistry of paraffin-embedded Human ovarian cancer tissue using CSB-PA072508(BPIFB1 Antibody) at dilution 1/40, on the right is treated with synthetic peptide. (Original magnification: ×200)
-
-
其他:
產(chǎn)品詳情
-
Uniprot No.:
-
基因名:BPIFB1
-
別名:BPIFB1 antibody; C20orf114 antibody; LPLUNC1 antibody; UNQ706/PRO1357BPI fold-containing family B member 1 antibody; Long palate antibody; lung and nasal epithelium carcinoma-associated protein 1 antibody; von Ebner minor salivary gland protein antibody; VEMSGP antibody
-
宿主:Rabbit
-
反應(yīng)種屬:Human
-
免疫原:Synthetic peptide of Human BPIFB1
-
免疫原種屬:Homo sapiens (Human)
-
標(biāo)記方式:Non-conjugated
-
抗體亞型:IgG
-
純化方式:Antigen affinity purification
-
濃度:It differs from different batches. Please contact us to confirm it.
-
保存緩沖液:-20°C, pH7.4 PBS, 0.05% NaN3, 40% Glycerol
-
產(chǎn)品提供形式:Liquid
-
應(yīng)用范圍:ELISA,IHC
-
推薦稀釋比:
Application Recommended Dilution ELISA 1:1000-1:5000 IHC 1:25-1:100 -
Protocols:
-
儲存條件:Upon receipt, store at -20°C or -80°C. Avoid repeated freeze.
-
貨期:Basically, we can dispatch the products out in 1-3 working days after receiving your orders. Delivery time maybe differs from different purchasing way or location, please kindly consult your local distributors for specific delivery time.
-
用途:For Research Use Only. Not for use in diagnostic or therapeutic procedures.
相關(guān)產(chǎn)品
靶點(diǎn)詳情
-
功能:May play a role in innate immunity in mouth, nose and lungs. Binds bacterial lipopolysaccharide (LPS) and modulates the cellular responses to LPS.
-
基因功能參考文獻(xiàn):
- BPIFA1 and BPIFB1 expressions are correlated with goblet cell metaplasia and inversely correlated with lung function parameters of airway obstruction (FEV1 and FEV1/FVC) in COPD patients. PMID: 29296079
- The G allele of rs1078761 may be detrimental to lung function in cystic fibrosis owing to decreased levels of BPIFA1 and BPIFB1. PMID: 25574903
- higher sputum concentrations of BPIFB1 were associated with changes of lung function over time, especially in current smokers with chronic obstructive pulmonary disease. BPIFB1 may be involved in the pathogenesis of smoking-related lung diseases. PMID: 25979078
- Autoimmunity targeting the lung-specific antigen BPIFB1 may contribute to the pathogenesis of interstitial lung disease. PMID: 24107778
- Results suggest that LPLUNC1 can inhibit inflammation and nasopharyngeal carcinoma (NPC) growth by downregulating the Stat3 pathway. PMID: 23708661
- LPLUNC1 delays nasopharyngeal carcinoma cell growth by inhibiting the MAP Kinase and cyclin D1/E2F pathways. PMID: 23650533
- It was shown that there was a significant increase in LPLUNC1 in the airways of patients with cystic fibrosis, but it is unclear if this increase influences the development of lung disease. PMID: 22767025
- These results demonstrate that LPLUNC1 is expressed in Paneth cells and likely plays a role in modulating host inflammatory responses to Vibrio cholerae infection. PMID: 21900486
- LPLUNC1 is an abundant, secreted product of goblet cells and minor mucosal glands of the respiratory tract and oral cavity and suggest that the protein functions in the complex milieu that protects the mucosal surfaces in these locations. PMID: 20237794
- LPLUNC1 is found to be down-expressed in 33 of 48 nasopharyngeal carcinoma biopsies. PMID: 12874788
- We found a significant association of cholera with a marker in the promoter region of LPLUNC1 (rs11906665), a member of a family of evolutionarily conserved innate immunity proteins PMID: 19212328
顯示更多
收起更多
-
亞細(xì)胞定位:Secreted.
-
蛋白家族:BPI/LBP/Plunc superfamily, Plunc family
-
組織特異性:Detected in duodenum mucosal crypts of cholera patients, near Paneth cells (at protein level). Detected in trachea, nasal septal epithelium and lung.
-
數(shù)據(jù)庫鏈接:
Most popular with customers
-
-
YWHAB Recombinant Monoclonal Antibody
Applications: ELISA, WB, IHC, IF, FC
Species Reactivity: Human, Mouse, Rat
-
Phospho-YAP1 (S127) Recombinant Monoclonal Antibody
Applications: ELISA, WB, IHC
Species Reactivity: Human
-
-
-
-
-